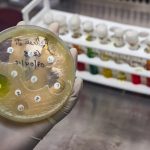
ECDC: Europa no está en camino de cumplir 4 de los 5 objetivos RAM previstos para 2030

El Director General de la Organización Mundial de la Salud (OMS) ha declarado la emergencia de salud pública de importancia internacional (ESPII) con arreglo al Reglamento Sanitario Internacional siguiendo el consejo de un Comité de Emergencias del RSI compuesto por expertos independientes que ha examinado los datos presentados por expertos de la OMS y de los países afectados. El Comité ha informado al Director General de que considera que el recrudecimiento de la mpox es una ESPII con potencial para extenderse aún más por los países de África y posiblemente fuera del continente.
Al declarar la ESPII, el Dr. Tedros ha manifestado: «La aparición de un nuevo clado (linaje) del virus de la mpox, su rápida propagación en el este de la República Democrática de Congo y la notificación de casos en varios países vecinos son noticias muy preocupantes. Además de los brotes de otros clados del virus de la mpox en la República Democrática del Congo y otros países de África, es evidente que se necesita una respuesta internacional coordinada para detener estos brotes y salvar vidas.»
La Directora Regional de la OMS para África, Dra. Matshidiso Moeti, ha declarado: «Se están llevando a cabo importantes esfuerzos en estrecha colaboración con las comunidades y los gobiernos, y nuestros equipos en los países están trabajando en primera línea con el fin de ayudar a reforzar las medidas para frenar la mpox. Con la creciente propagación del virus, estamos ampliando todavía más nuestra intervención por medio de una acción internacional coordinada con el objetivo de ayudar a los países a poner fin a los brotes.»
El Presidente del Comité, el profesor Dimie Ogoina, ha afirmado: «El recrudecimiento actual de la mpox en distintas zonas de África, junto con la propagación de una nueva cepa sexualmente transmisible del virus causante de la enfermedad, constituye una emergencia, no solo para África, sino para todo el planeta. La mpox no recibió la atención que se merecía en África, donde se originó, y más tarde provocó un brote mundial en 2022. Es hora de actuar con decisión para evitar que la historia se repita.»
Es la segunda vez en dos años que se determina una ESPII en relación con la mpox. Esta enfermedad, causada por un ortopoxvirus, se detectó por primera vez en humanos en 1970 en la República Democrática del Congo. La enfermedad se considera endémica de los países de África central y occidental.
En julio de 2022, el brote de mpox en múltiples países fue declarado una ESPII, ya que se propagó rápidamente a través del contacto sexual en una serie de países donde el virus no se había observado antes. Esa ESPII se declaró terminada en mayo de 2023 después de que se produjera un descenso sostenido de los casos en el mundo.

César Hernández, director general de Cartera y Farmacia del Ministerio de Sanidad:
Kilian Sánchez, secretario de Sanidad del PSOE y portavoz de la Comisión de Sanidad del Senado.:
Rocío Hernández, consejera de Salud de Andalucía:
Nicolás González Casares, eurodiputado de Socialistas & Demócratas (S&D - PSOE):
Juan José Pedreño, consejero de Salud de Murcia: